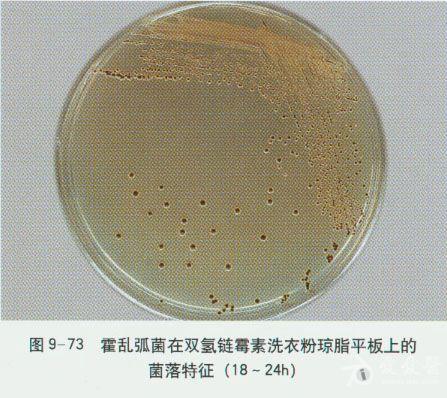
微生物图谱之弧菌科

荧光弧菌

弧菌
图片尺寸756x504
弧菌
图片尺寸495x381
弧菌
图片尺寸339x222
弧菌属的致病性
图片尺寸1192x1018
种类要有:哈维氏弧菌(育苗阶段容易出现,虾子发荧光),溶藻弧菌(红体
图片尺寸613x585![抗弧菌光合细菌的分离鉴定及对氨氮和亚硝态氮的降解特性[j].](https://i.ecywang.com/upload/1/img0.baidu.com/it/u=1518461842,708816808&fm=253&fmt=auto&app=138&f=JPEG?w=1039&h=500)
抗弧菌光合细菌的分离鉴定及对氨氮和亚硝态氮的降解特性[j].
图片尺寸1575x758
资深养殖户不传之秘,教你一招搞定弧菌病!__凤凰网
图片尺寸331x220
弧菌科
图片尺寸600x469
让养殖户头疼的弧菌只要这样就能简单解决
图片尺寸588x670
弧菌
图片尺寸383x284
副溶血弧菌革兰染色后在显微镜下的形态不过大家也不必恐慌!
图片尺寸746x580
结果他发现他手里的费氏弧菌已经不会发光了,随后他询问了周边的同事
图片尺寸611x338
谈"弧菌"色变,但是至今你还没有见过它长什么样子
图片尺寸640x640
谈"弧菌"色变,但是至今你还没有见过它长什么样子
图片尺寸1182x788
微生物图谱之弧菌科
图片尺寸447x398
给你一份弧菌的科普知识,赶快看看吧
图片尺寸640x1138
协和医生说|春节海边度假警惕"海洋中的隐匿杀手"——创伤弧菌
图片尺寸815x551
在脑子里养细菌的发光鱿鱼,美味之余还找到了抗击病菌的新思路
图片尺寸1024x768
给你一份弧菌的科普知识,赶快看看吧
图片尺寸640x1138
谈"弧菌"色变,但是至今你还没有见过它长什么样子
图片尺寸551x576



![抗弧菌光合细菌的分离鉴定及对氨氮和亚硝态氮的降解特性[j].](https://i.ecywang.com/upload/1/img0.baidu.com/it/u=1518461842,708816808&fm=253&fmt=auto&app=138&f=JPEG?w=1039&h=500)


















![抗弧菌光合细菌的分离鉴定及对氨氮和亚硝态氮的降解特性[j].](https://www.schinafish.cn/fileNFSCKX/journal/article/nfsckx/2021/5/20210016-D-2.jpg)